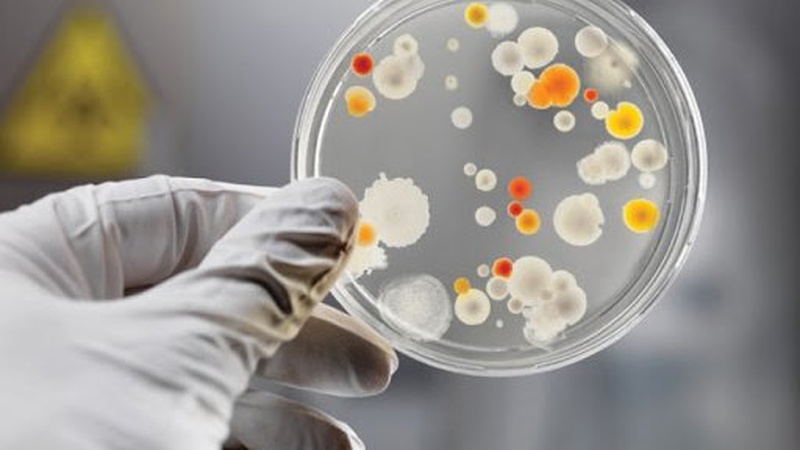
Опублікували відповідь на найпоширеніше питання про імуногенність вакцин

Неділя, 14 червня 2026

Сьогодні, 9 вересня, близько 18-ї години на одній із транспортних розв’язок Луцька сталась ДТП — зіткнулись два легковики

29 серпня в Україні вшановують пам’ять загиблих захисників

Імуногенність вакцин – це здатність вакцини стимулювати утворення антитіл та клітин. Іншими словами, це показник, що визначає відсоток тих, у кого відбулась імунна відповідь або сила імунної відповіді. Всі вакцини проти COVID-19, які зараз застосовують мають високу імуногенність.
Про це повідомляє Волинська обласна державна адміністрація.
Природний імунітет після перенесеної коронавірусної хвороби не гарантує того, що ви не захворієте знову на цю інфекцію. І важкість нового захворювання не залежить від того, як ви хворіли на COVID-19 раніше.
Натомість вакциновані люди дуже рідко хворіють на COVID-19. А якщо таке трапляється, то переносять хворобу набагато легше і з меншою кількістю ускладнень.
Це відбувається тому, що вакцини краще стимулюють утворення антитіл та Т-клітин, які знешкоджують вірус.
©2026 uaGit

Коментарі